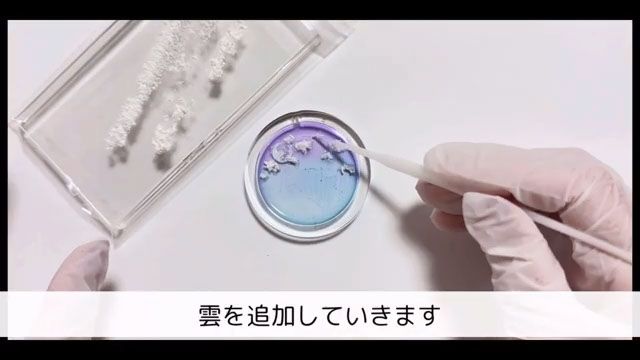

大人可愛い!桜×夜空のグラデーションシェイカーキーホルダー
2026年3月26日から2026年4月25日の間にお届けする「作家のためのレジン」定期便のパッケージは、ウグイスとネモフィラのデザインです。
そして、毎月のお楽しみであるオマケは桜のミニモールド、桜のスパンコール、桜のナスカンの3点です。(400g以上ご購入の方には「作家のためのレジン着色剤 濃縮カラーレジン10g」が1つ付いてきます。)
今回はこのオマケを活用して、春にぴったりなさくらのキーホルダーを制作しました。小さな桜のパーツをシェイカーフレームに装飾することで華やかに仕上がります。シェイカーの中に広がるグラデーションの夜空が美しい作品です。
この作品の大きな特徴は、細部までこだわった質感と奥行きのある風景表現。花びら部分には白、中心にはピンクのレジンを入れ、その境目を丁寧にぼかすことで、本物の桜のような柔らかな質感を表現しました。シェイカー部分には水色、青、紫の3色の着色レジンを使用しています。色の重なりを活かしてグラデーションを作り、そこによく練って伸ばした「練り消しの雲」と月のシールを組み合わせることで、奥行きのある幻想的な風景を描き出しました。
使う材料はおまけのパーツと基本のアイテム、そしてベーシックなテクニックばかりです。レジン初心者の方でも挑戦しやすいよう、きれいに仕上げるための細かなコツを含めて、詳しい作り方をご説明いたします。
本物のお花を使ったアクセサリーや、四季を感じるアクセサリーをお届けしますꕤ
YouTubeではアクセサリーの作り方やコツを投稿してます♬
作品はminneにて販売中✨
仲良くしてもらえると嬉しいです🙏💖
目次
- 1.材料と道具
- 2.作り方
- 3.まとめ
1.材料と道具
〈定期便オマケ〉
・桜のミニモールド
・桜のスパンコール
・桜のナスカン
作家のためのレジン
作家のためのレジン ぷっくりレジン
作家のためのレジン着色剤 濃縮カラーレジン10g
作家のためのレジン 「 UV/LEDコーティング液 8g 」
調色パレット
360° ライト
スティックライト
パール オフホワイト ケース入り レジン封入 シャカシャカ(S)
ヒートン
エンボスヒーター
練り消し
月シール
封入材 ブリオン デコパーツ 3サイズ 4色セット
平ヤットコ
シリコンブラシ
フィルムシート シェイカー用
お好きな封入材
丸いシェイカーモールド
2.作り方
カラーレジンを作ります。調色パレットを2つ用意してクリアレジン入れます。

片方にピンクと白を1滴ずつ、もう片方に白を1滴落とし入れます。

ムラがなくなるまでよく混ぜます。

エンボスヒーターで気泡を抜き、小さなものは爪楊枝などで取り除きます。

桜モールドの花びら部分に、白の着色レジンを入れます。爪楊枝やワイヤーなど、先の細いものを使うと綺麗に仕上がります。

花の真ん中にピンクの着色レジンを入れます。

濃いピンクを中心にぼかしながら乗せ、表と裏をそれぞれ3分ずつ硬化します。

丸いシェイカーモールドにクリアレジンを流し入れ、気泡を取り除いて3分硬化します。

調色パレットを3つ用意してクリアレジン入れます。

それぞれを水色、青、紫に着色してよく混ぜます。

エンボスヒーターで気泡を抜き、小さなものは爪楊枝などで取り除きます。

練り消しをよく練って伸ばし、雲を作ります。

水色の着色レジンを下側、紫の着色レジンを上側、青の着色レジンを真ん中に流します。

グラデーションを作りながら全体に伸ばします。

エンボスヒーターで気泡を抜き、3分硬化します。

クリアレジンを流して薄く塗り広げ、作った練り消し雲をお好みの場所に乗せます。

月のシールを乗せ、バランスを見ながら練り消し雲を追加して3分硬化します。
内側をコーティングして3分硬化します。

お好きな封入材を入れて、フレームにコーティング剤を塗ります。

フィルムを乗せて3分硬化します。

フレームにレジンを塗って、桜のパーツをお好みの場所に配置して3分硬化します。

ヒートンを差し込み、スティックライトで仮硬化します。

桜の中心にパールやブリオンを乗せて1分仮硬化します。

全体をコーティングして5分硬化します。

キーホルダーに加工して完成です。

3.まとめ
今月の「作家のためのレジン」定期便のオマケは、桜のミニモールド、桜のスパンコール、桜のナスカンの3点です。今回はオマケを活用したこれからの季節にぴったりなミモザのキーホルダーを、croccha公認クリエイターのmakimakiさんに制作していただきました。
さくらのパーツを作る際は、花びら部分に白、中心にピンクを入れ、その境目を丁寧にぼかしながら乗せるのがポイントです。こうすることで、本物の花びらのような柔らかな質感とリアルな表情を引き出すことができます。
メインのシェイカー部分には、水色、青、紫の3色の着色レジンを使用しました。この3色をグラデーション状に広げることで、澄んだ夜空のような美しい背景を描き出しています。さらに、よく練って薄く伸ばした「練り消しの雲」と月のシールを組み合わせることで、夜の静けさと奥行きを感じる幻想的な風景を表現しました。
難しい作業はなく、基本の知識とテクニックだけで作れるため、レジン初心者さんにとっても挑戦しやすいレシピです。特に桜の細かな成形や夜空のグラデーション作りは、道具の使い方ひとつで仕上がりに差が出るため、コツを意識しながら進めるとより完成度が高まります。
定期便のおまけで作る、春にぴったりな桜のチャーム。キーホルダーとしてはもちろん、お好みでバッグチャームなど様々なアイテムに加工して楽しめます。季節の贈り物や、大切な方へのプレゼントにもぜひいかがでしょうか。
この記事で紹介したアイテム
-
【10枚入り】フィルムシート シェイカー用 シャカシャカ(130×90mm)
¥400 ~ ¥900 税込 -
アクセサリー工具セット 単品 丸ヤットコ 平ヤットコ ニッパー
¥700 ~ ¥1,700 税込 -
360° ライト ダブルライトLED 最大60W 遮光カバー付き 取り替えアクリル板 crocchaオリジナル
¥480 ~ ¥6,800 税込 -
作家のためのレジン 「着色剤 濃縮カラーレジン10g 定番12色」セット 及び単品
¥600 ~ ¥6,700 税込お得割対象 -
エンボスヒーター 清原
¥4,290 ¥3,300 税込 -
【5個入り】調色カップ パレット 着色 カップ シリコンカップ
¥500 ¥400 税込 -
作家のためのレジン 200g
¥3,850 ¥3,500 税込 -
シリコンブラシ レジンブラシ アートブラシ 1本
¥380 税込 -
【高粘度】作家のためのレジン ぷっくりレジン 100g
¥2,200 ¥1,980 税込お得割対象 -
作家のためのレジン 「 UV/LEDコーティング液 8g 」1本
¥880 ¥800 税込お得割対象 -
パール オフホワイト ケース入り レジン封入 シャカシャカ(S)
¥480 ¥450 税込 -
crocchaオリジナル 雲 空レジン 固定用 ねりけし
¥180 ¥165 税込 -
封入材 ブリオン デコパーツ 3サイズ 4色セット
¥480 ¥450 税込 -
ヒートン 4色セット ゴールド シルバー ピンクゴールド ホワイトシルバー ケース入り
¥580 ¥550 税込 -
レジンシール 月の満ち欠け 【両面】レジンクラブ
¥910 税込 -
LEDミニスティックライト 充電式 crocchaオリジナル
¥1,280 ¥1,100 税込
レジンの関連する記事
-
リーフモールドを使ったお花のキーホルダーの作り方2026年4月26日から2026年5月25日の間にお届けする「作家のためのレジン」定期便のパッケージは、とのデザインです。 そして、毎月のお楽しみであるオマケはリーフのシリコンモールド、グリーンのラメ、キーリングの3点です。(400g以上ご購入の方には「作家のためのレジン着色剤 濃縮カラーレジン10gイエロー」が1つ付いてきます。) この作品の大きな特徴は、細部までこだわった質感と、複数のパーツを重ねて作る立体的な造形美です。 葉っぱパーツには緑や黄色、そして白を組み合わせたグラデーションを施し、境目を丁寧にぼかすことで自然の植物のような柔らかな質感を表現しました。さらに、それぞれの葉にホワイトやグリーンのラメを忍ばせることで、光の角度によってキラキラと輝く奥行きのある表情を引き出しています。 使う材料はおまけのパーツと基本のアイテム、そしてベーシックなテクニックばかりです。レジン初心者の方でも挑戦しやすいよう、気泡をきれいに抜く方法やバランスよく組み立てるための細かなコツを含めて、詳しい作り方をご説明いたします。
-
大人なミルキーカラーが美しい!ミモザのキーホルダーの作り方2026年2月26日から2026年3月25日の間にお届けする「作家のためのレジン」定期便のパッケージは、ウグイスとネモフィラのデザインです。 そして、毎月のお楽しみであるオマケは「スクエアモールド」「小分けミモザ」の2点。(400g以上ご購入の方には「作家のためのレジン着色剤 濃縮カラーレジン10g クリームソーダ」が1つ付いてきます。) 今回はこのオマケを活用して、これからの季節にぴったりなミモザのキーホルダーを制作しました。大人気のミモザのドライフラワーとレースフラワーを、ミルキーカラーに着色したレジンと組み合わせることでやわらかく春らしい雰囲気の作品に仕上がります。ふんわりとした色合いと可憐な花材の組み合わせが、季節感をそっと引き立ててくれます。 ミルキーカラーを美しく仕上げるポイントは、ほんの少しブラウンを加えること。わずかなニュアンスをプラスするだけで繊細さと奥行きが生まれ、ぐっと大人っぽいミルキーカラーに仕上がります。 また、ミモザのドライフラワーは気泡が入りやすい素材です。レジンが花材のすみずみまでしっかりと染み込んだことを確認してから硬化すると、透明感のあるきれいな仕上がりになります。 使うのはオマケと基本アイテム、そしてベーシックなテクニックを用いたレシピですので、レジン初心者さんにも挑戦しやすい作品です。きれいに仕上げるコツなどを含め、詳しい作り方をご説明いたします。
-
いちごミルクカラーが可愛い!バレンタインにぴったりなハートパズルキーホルダーの作り方2026年1月26日から2026年2月25日の間にお届けする「作家のためのレジン」定期便のパッケージは、心ときめくバレンタインデザインです。 そして、毎月のお楽しみであるオマケは「ハートパズルモールド」「ハートキー」「ラメパウダー」の3点。(400g以上ご購入の方には、Château Chaton«シャトーシャトンかのんさん監修の「作家のためのレジン着色剤 濃縮カラーレジン10g 夜空カラー6色」がランダムで1つ付いてきます。) 今回はこのオマケを活用し、いちごみるくカラーのハートパズルキーホルダーを作ってみました。透明感溢れるピンクといちごみるくカラーに着色したレジンを組み合わせることでバレンタインシーズンにぴったりな作品に仕上がります。 クリアピンクのボディの上にいちごみるくカラーのレジンを塗り広げ、クリームを描くデザインです。ハートのホログラムをいちごの果実に、星パーツをヘタに、そしてブリオン種に見立てています。可愛いいちごみるくカラーのキーホルダーは、バレンタインのラッピングに添えるのにも大活躍間違いなしです。 使うのはオマケと基本アイテム、そしてベーシックなテクニックを用いたレシピですので、レジン初心者さんにも挑戦しやすい作品です。きれいに仕上げるコツなどを含め、詳しい作り方をご説明いたします。
-
ゴールド模様が上品!メリーゴーランドキーホルダーの作り方2025年12月26日から2026年1月25日の間にお届けする「作家のためのレジン」定期便のパッケージは、椿と千鳥のデザインです。 そして、毎月のお楽しみであるオマケは「メリーゴーランドのモールド」「リボンナスカン」「ラメパウダー」の3点。(400g以上ご購入の方には、赤の着色剤もついてきます。) 今回はこのオマケを活用し、メリーゴーランドモチーフのキーホルダーを作ってみました。鮮やかな赤と上品なゴールドを合わせることで、まるで聖夜の遊園地のような、華やかで愛らしい表情に仕上がります。 メリーゴーランドの屋根部分は透明レジンと着色レジンを段階的に流し込み、ヒートンはレジンで厚めに補強して強度を高めました。また、馬のモチーフには白のジェルネイルを重ね塗りしてぷっくり感を出し、チェーンパーツでリアルな質感をプラスしています。 仕上げのゴールドには油性ペンを使用。マスキングテープで保護すれば、初心者さんでも綺麗に色分けが可能です。最後は両面を丁寧にコーティングし、ライトを回転させながら当てることで未硬化を防ぎ、ツヤツヤに硬化させます。 難しい工程はなく、ポイントを押さえれば初心者さんでも可愛く仕上げられるレシピです。自分だけの特別なメリーゴーランドで、冬のハンドメイドを楽しんでみましょう!
-
アイシングクッキーみたいで可愛い!きらめくクリスマスのジンジャーマンクッキーシェイカーの作り方2025年11月26日から12月25日の間にお届けする「作家のためのレジン」定期便のパッケージは、クリスマスのデザインです。そして毎月のお楽しみであるオマケは、クリスマスモールド、スターナスカン、そしてラメパウダーの3点です。(400g以上ご購入の方には着色剤も付きます。) 木々に淡いイルミネーションが灯り、街中にクリスマスの気配が広がりはじめる季節。 そんなわくわくした雰囲気にぴったりなジンジャーマンクッキーモチーフのシェイカーキーホルダーを作ってみました。 温かなブラウンに白いアイシング風ラインを合わせることで、まるで本物のお菓子のような愛らしい表情に。 キラッと輝くパーツが聖夜のきらめきをそのまま閉じ込めたような仕上がりになります。 細かな凹みに異なるカラーのレジンを入れることでアイシングクッキーのようなデザインが生まれ、とても可愛らしく仕上がります。 目・口・ほっぺの表情付けや気泡処理、はみ出したレジンの拭き取りなど丁寧な下準備が完成度を大きく左右します。 マフラーやキャンディ、ヒイラギなどの小物パーツを組み合わせたり、シェイカー内部にクリスマスらしいビーズやホログラムを封入したりとアレンジの幅も広がります。 難しい工程はなく、ポイントを押さえれば初心者さんでも可愛く仕上げられるレシピです。 シェイカーをきれいに作るための基本的な作り方に加え、未硬化を防ぐコツもしっかりとご紹介いたします。
-
秋カラーが可愛い!紅葉たっぷりなモーテルキーホルダーの作り方2025年10月26日から11月25日の間にお届けする「作家のためのレジン」定期便のパッケージは、ティーセットのデザインです。そして毎月のお楽しみであるオマケは、モーテルキーのモールド、キーリングホルダー、そして紅葉のスパンコールの3点です。 木々が色づき空気に少しずつ秋の深まりを感じる季節。そんな今の気分にぴったりな、夕焼けのような温かみのあるオレンジの着色レジンに紅葉のスパンコールを合わせたモーテルキーホルダーを作ってみました。ほんのり透ける色合いやキラリと光るパーツが、秋の情景をそのまま閉じ込めたような仕上がりになります。 着色レジンにラメやスパンコールを加え、透明感を出すための気泡抜きや表面をぷっくり仕上げるテクニックもご紹介。レジンをモールドに流し込む順番や硬化のコツを押さえれば初心者さんでもきれいに作れます。着色剤やラメ、シールの組み合わせを工夫することで自分らしい秋のアレンジが楽しめるレシピです。 透明感のある仕上がりにするための気泡の抜き方や、表面をぷっくりと仕上げるコツも丁寧にご説明いたします。